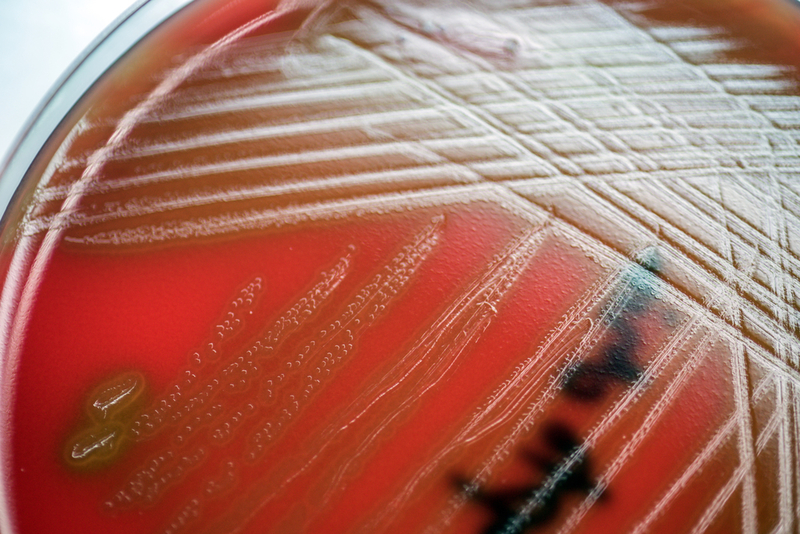

Streptococcus suis, a species of bacterium found in many parts of world
UNI Jul 06, 2018
Streptococcus suis is a species of bacterium found in many parts of the world where pigs are raised, but is also occasionally found from wild boars, horses, dogs, cats and birds. Human infection was first described in the 1960s and is increasingly recognized.
It is unclear, however, whether this reflects a true rise in incidence or whether it is being diagnosed more frequently due to increased awareness by physicians. Infection in pigs is usually asymptomatic, but can result in septicaemia (blood poisoning), meningitis, pneumonia and arthritis.
Although rarely diagnosed in Europe, there is some evidence that Streptococcus suis is a not uncommon cause of bacterial meningitis in humans residing in some parts of South-east Asia. It usually does not cause outbreaks, but occurs in a sporadic manner.
The most important risk factor in acquiring the infection is contact with pigs or uncooked pig products, typically farmers, veterinary personnel, abattoir workers and butchers. Individuals who are immunosuppressed, including those who have had their spleens removed, are also at increased risk.
Transmission to humans is most likely to occur through wounds on the skin, including minor abrasions. But infection via ingestion or through mucous membranes—such as the conjunctiva—has been suspected in some cases. The incubation period ranges from a few hours up to three days. Classically, infection in humans produces a fever and signs of meningitis (headache, vomiting, neck stiffness, intolerance of light and decreased level of consciousness). Hearing loss, which is generally permanent and affects around 50 per cent of those infected, occurs due to involvement of the auditory nerve. Arthritis and pneumonia are also possible complications.
Diagnosis is made by the recovery of bacteria from the cerebrospinal fluid, blood or joint fluid, if arthritis occurs as a result of infection. The bacterium can be grown in culture. Polymerase Chain Reaction (PCR) can also be used to make a diagnosis. If diagnosis is early, prompt treatment with appropriate antibiotics will lead to recovery. Delay in treatment, however, will adversely affect survival.
-
Exclusive Write-ups & Webinars by KOLs
-
Daily Quiz by specialty
-
Paid Market Research Surveys
-
Case discussions, News & Journals' summaries